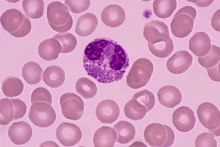

Institutes and Centers
Biosphere 2
A living laboratory for controlled scientific studies of Earth systems, an arena for scientific discovery and discussion, and a provider of public education.
Image

Institute Link
Pagination
- Previous page
- Page 2